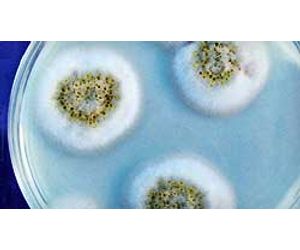

- Home
- Companies
- EFI Global, Inc.
- Services
- Laboratory Services

Laboratory Services
Our technical laboratories are located in Houston, Texas and Sacramento, California and offer a wide range of chemical and microbiological testing services. Our laboratories are staffed with degreed, trained and experienced microbiologists and chemists who perform a variety of tests to support fire investigations, indoor air quality (IAQ) assessments, mold evaluations and failure analysis. We provide the highest quality analysis, rapid turnaround times and consulting expertise on chemical, bacterial and fungal issues.
While our chemical laboratories specialize in fire debris analysis, these laboratories also provide testing of fuels, oils, polymers and constituents relating to environmental issues in air, soil and water. Our microbiological services focus on testing of fungal and bacterial growth in indoor environments and water. Our chemical and microbiological tests support scientific analysis of cause and origin, environmental compliance, subrogation and litigation assistance.
The scope of our labratory services consists of:
EFI Global maintains two chemical laboratories providing a full range of material and chemical testing. Both laboratories are fully equipped with state-of-the-art instruments and experienced chemists specializing in analysis of forensic fire debris, natural gas, liquefied petroleum gas (LPG) and polymers. Our chemistry personnel are degreed professionals with expert witness testimony experience for industrial, civil and criminal matters.
Below is a partial list of chemistry laboratory services available.
Forensics
- Fire debris Analysis by GC/MS for All Samples
- Ignitable Liquids by ASTM E1618
- Plastics Identification
- Thermal Properties for Solids and Liquids
- FTIR (Fourier Transform Infrared Spectroscopy)
- TGA (Thermal Gravimetric Analysis)
- Analysis for Explosives and Flare Residues
Fuels and Oils
- Propane & Natural Gas Analysis for Composition & Odorants
- Flash Point Analysis for Flammable and Combustible Liquids
- Fuel Identification
- Contamination of Motor Fuels
Environmental
- Wildfires: Testing for Soot, Char and Ash
- Air Sampling Analysis for Volatile Organic Compounds (VOC)
- GC/MS Scan of Soil & Water for VOCs

Our microbiology laboratories support a wide range of indoor air quality, mold and other environmental investigations conducted throughout the U.S. We specialize in the analysis of indoor air quality samples for common fungi, yeasts and bacteria found in residential and commercial properties. In addition to fungal analysis, we offer an extensive list of services for the identification of bacteria in indoor environments and drinking water.
Our laboratories are also participants in the American Industrial Hygienist Associations Environmental Microbiology Proficiency Analytical Testing Program (EMPAT).
Below is a partial list of our services.
Non-Viable Fungi
- Air Sample Analysis.
- Direct Exam: Tape Lift, Bulk, Wipe and Swabs
- Wood Degradation Analysis
Viable Fungi
- Plate Impactors
- Bulk/Surface, Wipe, Swabs and Dust Samples
Bacterial Identification
- Bacterial Count & Gram Stain Enumeration: Plate Impactors, Bulk, Wipe, Swabs and Dust Samples
Water Quality Testing
- Quantification of Escherichia Coli and Other Fecal Coliforms